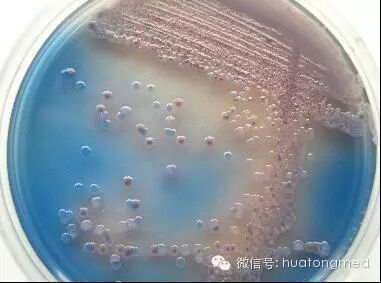

病原微生物培养基的分类
按照培养基的物理状态分
培养基按其物理状态可分为固体培养基、液体培养基和半固体培养基三类。
(1)固体培养基。是在培养基中加入凝固剂,有琼脂、明胶、硅胶等。固体培养基常用于微生物分离、鉴定、计数和菌种保存等方面。
用于微生物分离,鉴定,计数。如图,微生物分离成菌落、菌苔。图中为大肠杆菌菌落,是用涂布平板法得到。
(2)半固体培养基。是在液体培养基中加入少量凝固剂而呈半固体状态。可用于观察细菌的运动、鉴定菌种和测定噬菌体的效价等方面。
用于观察微生物运动特征。如图,左侧试管中微生物不运动,而右侧试管中微生物运动,因而两试管中现象不同。

(3)液体培养基。液体培养基中不加任何凝固剂。这种培养基的成分均匀,微生物能充分接触和利用培养基中的养料,适于作生理等研究,由于发酵率高,操作方便,也常用于发酵工业。
用于观察微生物生长状态。如图,此例中左侧为表面生长,右侧为沉淀生长,中间两个为均匀混浊生长。

按照微生物的种类分
培养基按微生物的种类可分为细菌培养基、放线菌培养基、酵母菌培养基和霉菌培养基等四类。
(1)常用的细菌培养基有营养肉汤和营养琼脂培养基。
(2)常用的放线菌培养基为高氏1号培养基。
(3)常用的酵母菌培养基有马铃薯蔗糖培养基和麦芽汁培养基。
(4)常用的霉菌培养基有马铃薯蔗糖培养基、豆芽汁蔗糖(或葡萄糖,葡萄糖比较昂贵)琼脂培养基和察氏培养基等。

按照培养基用途分
培养基按其特殊用途可分为基础培养基、加富培养基、选择性培养基和鉴别培养基。
(1)基础培养基。是含有一般微生物生长繁殖所需基本营养物质的培养基。牛肉膏蛋白胨培养基是最常用的 基础培养基。
(2)加富培养基。是在基础培养基中加入血、血清、动植物组织提取液制成的培养基。用于培养要求比较苛刻的某些微生物。
(3)选择性培养基。是在普通培养基中加入特殊营养物质或化学物质,以抑制不需要的微生物的生长,有利于所需微生物的生长。用于将某种或某类微生物从混杂的微生物群体中分离出来。
